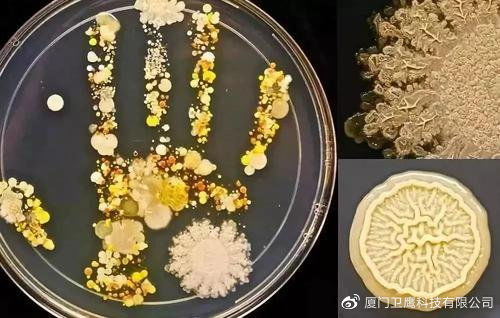
߻ʲô

肌酐高会出现什么疾病
生活百科 2025-11-13 16:20生活百科www.xingbingw.cn
肌酐高,肾功能警报拉响
血肌酐的升高犹如一个无声的警钟,提醒我们肾功能可能出现了减退。当身体内的肌酐水平出现异常,往往是肾脏健康的一个重大信号。让我们深入了解这一健康隐患可能带来的疾病表现。
肾功能减退分为急性和慢性两种类型。急性肾功能衰竭,其起病急骤,病情进展迅速,仿佛一场突如其来的风暴。患者可能出现少尿、水肿等症状,高血压也随之而来。若不及时干预,病情可能迅速恶化,引发心力衰竭和消化系统的不适,如恶心、呕吐等。
相对于急性肾功能衰竭的迅猛势头,慢性肾衰竭则是慢性肾脏疾病逐渐发展的结局。在疾病早期,患者可能没有明显的不适感。但当病情进展到四期后,消化系统的症状开始显现,如恶心、纳差、呕吐等。随着肾功能的逐渐恶化,患者会感到乏力,伴随顽固性高血压、水肿等。到了晚期,可能引发慢性心力衰竭,甚至中枢神经系统的问题,如尿毒症脑病等严重病症。
这些疾病的表现虽然各异,但都是肌酐升高、肾功能减退的明确信号。一旦发现身体出现异常症状,应立即就医检查,以便早期干预和治疗。生活中的健康饮食、规律作息和定期体检,都是预防肾功能疾病的关键措施。通过及时了解并应对肌酐高的问题,我们可以维护肾脏健康,保持身体的整体健康状态。不要忽视身体的任何不适,因为它们可能是潜在健康隐患的警示。
上一篇:结石病治疗
下一篇:没有了
